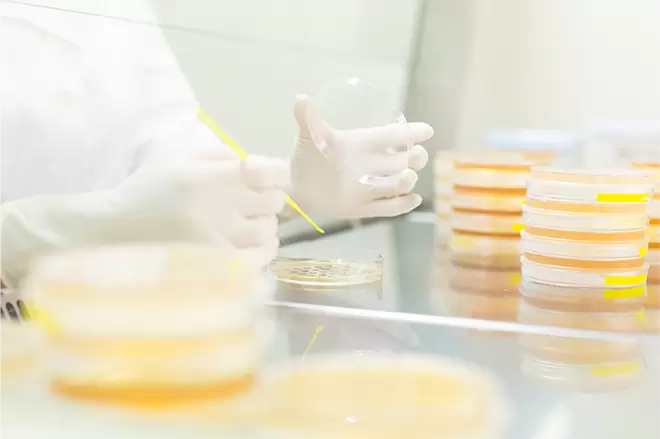

It’s time to feel good again—healthy, light, and carefree.

The Grisso® Team
Behind our products stands a passionate and dedicated team of scientists and clinicians specializing in microbiome research, united by the vision of a women’s health advocate with firsthand experience of these challenges.




About Our Founder
“My background is that of a passionate women's health advocate, a path forged from a shared journey with a close-knit team of women. We were once a strong team at a public company, and we remained close friends, supporting each other through different life stages—as single women, partners, and mothers. This gave me a unique and deeply personal understanding of the common health challenges women face, and the frustrating search for solutions that are not only effective but also built on a foundation of absolute trust and scientific integrity. “
“While I am not a scientist, my quest for a lasting solution for our shared struggles led me to the powerful science of targeted probiotics. This discovery became the catalyst for building Grisso. My role has been to champion this vision and bring together a world-class team of dedicated scientists and clinicians, empowering them with the resources—including our state-of-the-art manufacturing facilities and global research partnerships—to create the scientifically rigorous, award-winning products we once searched for.” --Pamela Garcia

Our Quality Promise
- World Health Organization (WHO) good manufacturing practices
- Current Good Manufacturing Practices(cGMP)
- NSF International good manufacturing practices
- International Probiotics Association manufacturing guidelines
- U.S. Food and Drug Administration (FDA) Generally Recognized As Safe (GRAS) Standard
- Food Safety System Certification (FSSC)
- International Standards Organization (ISO) quality management criteria



